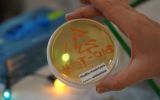

Zdrowie pod choinkę
W dniu 11 grudnia 2024r. w holu głównym budynku A1 Uniwersytetu Rzeszowskiego już po raz trzeci odbyła się akcja „Zdrowie pod choinkę”. Inicjatywa ta organizowana przez Studenckie Koło Naukowe Położnych i Samorząd Studentów Uniwersytetu Rzeszowskiego ma niezmiennie to samo pytanie „O czym porozmawiać przy świątecznym stole?”.
Celem naszej akcji jest promocja profilaktyki zdrowotnej, podczas której wszystkie zainteresowane osoby mogły skorzystać z konsultacji z zakresu zdrowia i profilaktyki zdrowotnej, warsztatów praktycznych i badań wykonywanych przez studentów Studenckich Kół Naukowych: SKN Położnych, które reprezentowały Gabriela Sołga, Kinga Tadla, Klaudia Wal, Karolina Lis, Angelika Misiak, Natalia Czernik, Magdalena Dwornik, Aleksandra Gołębiewska i Weronika Fajt; SKN „Bio-Tech”; SKN Psychiatrii; SKN Dietetyków; SKN „Habitus” Fascynacje Postawą Ciała; SKN „Młoda Elektroradiologia”; SKN Immunologii; SKN „Rech-Tech”; SKN Promotorów Zdrowia LaLonda; SKN Geriatrii i profilaktyki zdrowia oraz Akcja „Uśmiech w prezencie”.
Studenckie Koło Naukowe Położnych w tym roku promowało zdrowie w zakresie: zapobiegania nowotworom gruczołu piersiowego i szyjki macicy, pierwszej pomocy u noworodka oraz bezpieczeństwa w zakresie podnoszenia i noszenia niemowląt.
Na akcję zostały przygotowane domowe pierniczki, które upiekliśmy we współpracy z Kołem Naukowym Technologów Żywności „Ferment”. Zdecydowanie wypieki cieszyły się dużą popularnością i podkreślały przedświąteczny charakter wydarzenia.